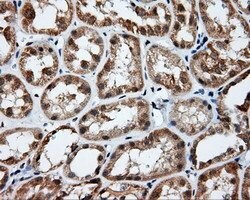
PIM2 Mouse anti-Human, Clone: OTI8B4, lyophilized, TrueMAB 100 &mu;g | Buy Online | Origene Technologies | Fisher Scientific

missing translation for 'onlineSavingsMsg'
Learn More
Learn More
PIM2 Mouse anti-Human, Clone: OTI8B4, lyophilized, TrueMAB™

Description
Reconstitute with PBS (pH 7.3) and recommend to perform another round of desalting process using Product No. 7KMWCO
PIM proteins (PIM-1, PIM-2 and PIM-3) are oncogene-encoded serine/threonine kinases. PIM-2 is highly homologous to Pim-1 with similar oncogenic functions. PIM-2 is most abundantly expressed in hematopoietic tissues, spleen, thymus, and peripheral blood leukocytes, as well as in testis, small intestine, and colon. PIM-2 overexpression promotes resistance to a host of apoptotic stimuli; its expression is negatively regulated by growth factor depletion. Increased levels of PIM-2 has also been observed in certain cancers.
Specifications
Specifications
| Antigen | PIM2 |
| Applications | Flow Cytometry, Immunocytochemistry, Immunofluorescence, Immunohistochemistry (Paraffin), Immunoprecipitation |
| Classification | Monoclonal |
| Clone | OTI8B4 |
| Conjugate | Unconjugated |
| Formulation | PBS with 8% trehalose and no preservative; pH 7.3 |
| Gene | PIM2 |
| Gene Accession No. | Q9P1W9 |
| Gene Alias | Pim-2 proto-oncogene, serine/threonine kinase |
| Gene Symbols | PIM2 |
| Show More |
Product Title
By clicking Submit, you acknowledge that you may be contacted by Fisher Scientific in regards to the feedback you have provided in this form. We will not share your information for any other purposes. All contact information provided shall also be maintained in accordance with our Privacy Policy.
Spot an opportunity for improvement?